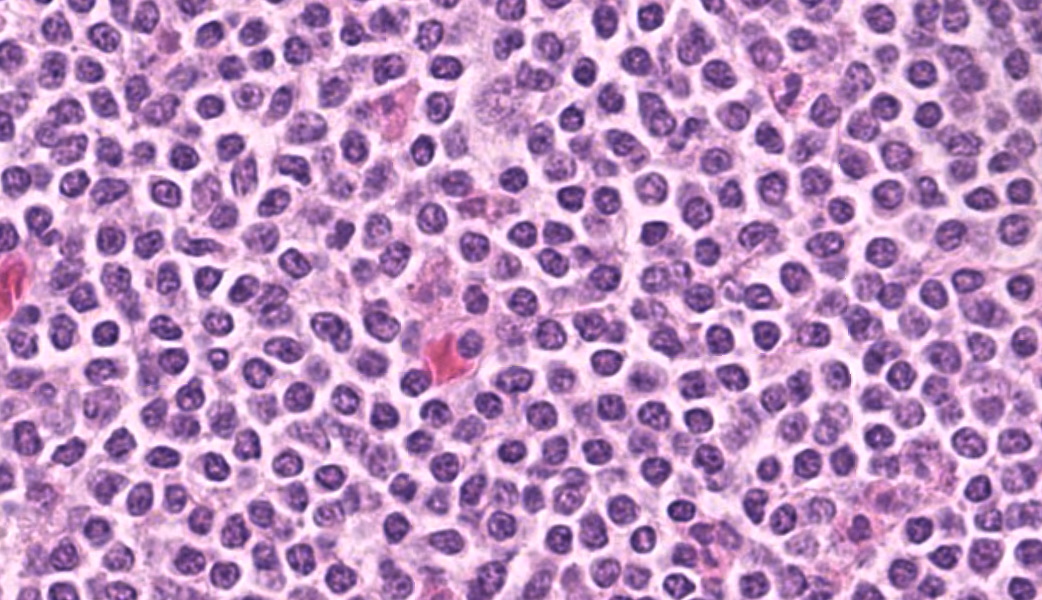

Wednesday Slide Conference, 2025-2026, Conference 6, Case 4
Signalment:
Dromedary camel (Camelus dromedarius), adult femaleHistory:
A lactating adult dromedary camel was one of two breeding females which had been recumbent for the last 2 to 4 days; both were in poor body condition. Other camels in the breeding herd were also in low body condition. Both recumbent animals were eating and drinking and were up to date with vaccinations. There had been no change in condition in response to worming and anticoccidial treatments. A pasture assessment was conducted, and the amount of feed available was determined to be inadequate for the lactating camels. Bloods were taken from both camels and supplementary feeding initiated.The second camel began to put on weight and became ambulatory after supplementary feeding, however the first female camel was unable to rise without assistance and continued to loose condition. The animal was euthanized and a post mortem conducted.
Gross Pathology:
Necropsy examination revealed that the ventral 40-50% of both lungs were pale-pink to white with a firm consistency and smooth surface on cross section. The paratracheal and parabronchial lymph nodes were diffusely markedly enlarged and were white on the cut surface. Other viscera appeared grossly normal.Laboratory Results:
HematologyOn the blood smear collected during the initial clinical exam, numerous large atypical lymphocytes were observed throughout the smear.
|
Test |
Normals |
Units |
Female camel 1 (euthanized) |
Female camel 2 (recovered) |
|
PCV (%) |
27-45 |
% |
24 |
22 |
|
RBC |
10.5-17.2 |
1012/L |
6.32 |
5.76 |
|
Hemoglobin |
11.3-19.0 |
g/dL |
11.0 |
9.2 |
|
MCV |
22-29.5 |
fL |
38 |
38 |
|
MCHC |
38-46 |
g/dL |
46 |
42 |
|
MCH |
9.6-12 |
pg |
17 |
16 |
|
WBC |
6.0-20.9 |
109/L |
194.6 |
19.3 |
|
Neutrophils |
2.0-13.3 |
109/L |
21.41 |
17.18 |
|
Band Neutrophils |
0.0-2.9 |
109/L |
0 |
0 |
|
Lymphocytes |
2.1-6.8 |
109/L |
173.19 |
2.12 |
|
Monocytes |
0.0-0.6 |
109/L |
0.0 |
0.0 |
|
Eosinophils |
0.0-3.0 |
109/L |
0.0 |
0.0 |
|
Basophils |
0.0-0.3 |
109/L |
0.0 |
0.0 |
|
Nucleated RBC |
/100wbc |
0 |
Occasional |
|
|
Reticulocytes |
% |
0 |
1 |
|
|
Platelets |
Adequate |
Adequate |
Serum Biochemistry
|
Test |
Normals |
Units |
Female camel 1 (euthanized) |
Female camel 2 (recovered) |
|
GGT |
0-60 |
U/L |
19 |
17 |
|
GLDH |
0-20 |
U/L |
4 |
4 |
|
AST |
0-320 |
U/L |
123 |
150 |
|
Bilirubin |
0.1-3.2 |
?mol/L |
2.0 |
3.1 |
|
CK |
0-750 |
U/L |
423 |
1693 |
|
Urea |
5.0-12.4 |
mmol/L |
11.1 |
9.4 |
|
Creatinine |
0-288 |
?mol/L |
101 |
119 |
|
Phos |
1.5-3.4 |
mmol/L |
1.2 |
1.98 |
|
Urea/Creatinine |
0.00-0.07 |
0.11 |
0.08 |
|
|
Protein |
54.0-75.0 |
g/L |
53.8 |
48.1 |
|
Albumin |
25.0-45.0 |
g/L |
16.2 |
20.4 |
|
Globulins |
15.9-41.0 |
g/L |
37.6 |
27.7 |
|
Albumin/Globulins |
1.3-3.3 |
0.4 |
0.7 |
|
|
?-Hydroxybutyrate |
0.00-0.50 |
mmol/L |
0.02 |
0.01 |
|
Calcium |
1.9-2.7 |
mmol/L |
2.1 |
2.11 |
|
Magnesium |
0.7-1.3 |
mmol/L |
0.96 |
0.92 |
|
Haptoglobin |
1.0-2.0 |
g/L |
0.69 |
0.58 |
|
Serum Hemoglobin |
0.0-0.2 |
g/dL |
0.04 |
0.04 |
|
Glutathione Peroxidase |
15-200 |
U/gHb |
69 |
170 |
Bacterial Culture, Lungs
Moderate pure growth of Streptococcus agalactiae
Enzootic Bovine Leukosis ELISA
Camel 1 seronegative
Immunohistochemical markers
|
Marker |
Cell type |
Tissue |
Number of positive cells |
Positive cell distribution |
|
CD79b |
B Cell |
Lung |
+++ |
Majority of cells within neoplastic infiltrate, scattered cells within peribronchial and peribronchiolar spaces, interlobular and alveolar septae and alveolar lumen |
|
Lymph node |
+++ |
The majority of cells within the cortex and moderate numbers (30-50% of cells) within the medulla |
||
|
Spleen |
+++ |
Majority of cells within red and white pulp |
||
|
CD3 |
T Cell |
Lung |
+ |
Scattered throughout parenchyma, and small numbers accompanying neoplastic infiltrate |
|
Lymph node |
++ |
Moderate numbers multifocally throughout the medulla |
||
|
Spleen |
+ |
Predominantly around blood vessels |
Microscopic Description:
Camel; LungDescription Multifocally throughout the section, expanding the lamina propria of larger airways, multifocally invading the airway epithelium, expanding numerous alveolar septae and infiltrating into interlobular septae and the pleural space, there is a densely cellular lymphoid neoplasm. The neoplasm is made up of sheets and rows of closely packed round cells supported by a fine pre-existing fibrous stroma. The neoplastic cells contain nuclei 5-7µm in diameter and have indistinct cytoplasmic borders, scant amphophilic cytoplasm, round to ovoid paracentral nuclei with coarsely clumped chromatin with moderate numbers of cells possessing a single nucleolus. Throughout the neoplastic cells there is mild anisokaryosis and anisocytosis. Mitotic figures numbering 5 per 2.37mm2 with occasional bizarre mitoses. Multifocally the neoplastic cells closely surround and infiltrate the tunica media of small blood vessels. Numerous alveolar spaces are filled with eosinophilic fibrillar material (fibrin) admixed with abundant neutrophils and foamy macrophages, while others contain large amounts of homogenous eosinophilic material (edema). Multifocally some alveolar spaces are expanded and ruptured (emphysema). Bronchioles contain moderate numbers of neutrophils and macrophages admixed with strands of hypereosinophilic fibrillar material (fibrin) with neutrophils transmigrating across the respiratory epithelium. There is occasional loss of type I pneumocytes with replacement by type II pneumocytes.
Camel; Paratracheal Lymph NodeDescription Multifocally the normal architecture of the cortex, paracortex and medulla is disrupted and replaced by a densely cellular neoplasm composed of lymphoid cells. The neoplasm is comprised of sheets of closely packed small round cells with nuclei 5-7µm in diameter. Cells are mostly round with indistinct cytoplasmic margins, scant basophilic or eosinophilic cytoplasm, high nuclear to cytoplasmic ratio, and a paracentric nucleus with coarsely clumped chromatin. There is mild anisocytosis and anisokaryosis. There is an average of 12 mitoses per 2.37mm2. Within the capsule of the lymph node there are small aggregates of neoplastic cells organized into sheets.
Contributor's Morphologic Diagnoses:
Lung and Lymph node; B-cell lymphomaLung; bronchopneumonia, fibrinosuppurative, multifocal, severe, subacute, with type II pneumocyte hyperplasia.
Contributor's Comment:
In this case, neoplastic cells were also found in the liver, spleen and heart of the camel. No neoplastic cells were found in the kidneys or in two sections of bone marrow (rib and sternum). The presence of atypical lymphocytes within the peripheral blood collected at the initial clinical examination greatly aided the diagnosis of lymphoma or leukemia in this case (Figure 1) and allowed the clinician to understand why this animal did not improve like the others in the herd once nutrition was improved. The neoplastic cells observed in the peripheral blood was suspected to be secondary to the lymphoma, given that no neoplastic cells were found within the bone marrow of the bones examined histopathologically. Leukemia is a feature of less than 20% of lymphomas in animals and is more commonly a feature of T-cell lymphomas.9 Leukemia is most likely observed when the lymphoma invades the bone marrow or spleen, the latter of which contained neoplastic cells in this case.9 In this case a B-cell phenotype was confirmed via immunohistochemistry (Figures 7-11).There are only a few reports in the literature describing lymphoma in dromedary camels. Similar to this case, the disease is typically reported in adult animals (>7 years) and has been reported in both male and female camels. Common clinical presentations include weight loss, anorexia, polyuria and polydipsia, with one report also describing peripheral lymphadenopathy and bilateral masses in the conjunctiva of one animal.3,4,6 Peripheral lymphocytosis, sometimes with significant atypia in circulating lymphocytes and lymphoblasts, has been reported occasionally but is not always a feature of the disease in dromedary camls.3,7
Necropsy findings typically include disseminated nodules which can be found in various organs including the liver, spleen, lungs, kidneys, bladder and intestines. Often multiple mesenteric and/or mediastinal lymph nodes are enlarged.3,4,6
Histologically, lymphomas in dromedary camels are described as a highly cellular neoplasm often effacing the normal architecture of the tissues, made up of sheets of lymphoid cells with scant cytoplasm and distinct cell margins. There is some variability in the cellular morphology including anisocytosis and anisokaryosis, indistinct nucleoli to multiple nucleoli present and in one case multinucleated cells were observed.3,4,6
In contrast to this case, all cases in the literature from dromedary camels were identified as T-cell lymphomas. In those cases, lymphocyte lineage identification was performed using immunohistochemistry and identified the neoplastic cells as CD3 (pan T-cell) positive and either CD20 or CD79a (pan B-cell markers) negative.3,4 More recently, flow cytometry has been used to further classify a multicentric T-cell lymphoma as a gd T-cell lymphoma and a combination of CD4 and WC-1 markers.4 Other markers which have been used in the literature to differentiate round cell neoplasms in camelids include PAX-5, CD79b (B-cell markers), CD5 (T-cell marker), MUM1 (plasma cell marker), CD18 and CD68 (histiocyte markers).1,4,6,8
In other camelids (llamas and alpacas), lymphoma is identified as one of the most common types of neoplasia, and both T-cell and B-cell as well as non-T and non-B cell lymphomas have been reported.1,8 Disseminated lymphoma has been reported in juvenile alpacas1 and lymphoma of the liver has been reported in a juvenile llama.8 Multicentric lymphoma has been reported in both adult alpacas and llamas and the distribution of lesions in organs is similar to that described for dromedary camels with lesions also seen in the spleen, stomach, trachea and bone marrow.1,8
Contributing Institution:
Elizabeth Macarthur Agricultural Institute, New South Wales Department of Primary IndustriesWoodbridge Road, Menangle, NSW, 2568
https://www.dpi.nsw.gov.au/dpi/about-us/research-and-development
JPC Diagnoses:
- Lymph node and lung:
- Lung:Bronchopneumonia, fibrinosuppurative, subacute, multifocal, severe, with type II pneumocyte hyperplasia.
JPC Comment:
This camel just had to be contrarian in that it had a lymphoma of B-cell origin instead of T-cell like almost every other camel lymphoma out there. This case provided a great two-fer of a late-stage lymphoma and bronchopneumonia, and the contributor provides a thorough and well-written comment on lymphomas in camels.Another primary point of discussion, and one that was briefly mentioned by the contributor, was the classification of this case as a lymphoma a leukemia given that there were intravascular atypical lymphocytes. Given that there was no bone marrow involvement, though, a lymphoma was the consensus. According to the WHO guidelines in dogs, a stage 5 lymphoma is characterized as generalized lymphadenopathy (involving both thoracic and abdominal nodes) with hepatosplenomegaly and involvement of either bone marrow, the CNS, or another extranodal site (such as the lungs).10 This stage would best fit with the histologic findings in this case, as there was multiorgan involvement. Stage V is further classified into 5a or 5b, with either no clinical signs or apparent clinical illness, respectively, which would classify this camel?s lymphoma as a stage 5b due to the obvious clinical signs described in her case. In human medicine, the fifth stage is not utilized; their grading scheme ends at stage 4.5 Whether either (or neither) of these classification schemes fits with lymphoma in camelids, however, is currently unknown and will require additional studies.
References:
- Aboellail TA. Pathologic and immunophenotypic characterization of 26 camelid malignant round cell tumors. J Vet Diagn Invest. 2013;25(1):168?172.
- Desmirean M, Deak D, Rus I, Dima D, Iluta S, Preda A, Moldovan T, Roman A, Tomuleasa C, Petrushev B. Paraneoplastic hypereosinophilia in a patient with peripheral T cell lymphoma, not otherwise specified. Med Pharm Rep. 2019;92(4):421-426.
- Heather A. Simmons, Scott D. Fitzgerald, Matti Kiupel, David R. Rost, Robert W. Emery. Multicentric T Cell Lymphoma in a Dromedary Camel (Camelus dromedarius). Journal of Zoo and Wildlife Medicine. 2005;36(4):727?729.
- Ibrahim A, Hussen J, Shawaf T, Al-Hizab FA, Kiupel M. Disseminated gamma-delta T-cell lymphoma in a dromedary camel. Veterinary Record Case Reports. 2023;n/a(n/a):e650.
- Khoury JD, Solary E, Abla O, Akkari Y, Alaggio R, Apperley JF, Bejar R, Berti E, Busque L, Chan JKC, Chen W, Chen X, Chng WJ, Choi JK, Colmenero I, Coupland SE, Cross NCP, De Jong D, Elghetany MT, Takahashi E, Emile JF, Ferry J, Fogelstrand L, Fontenay M, Germing U, Gujral S, Haferlach T, Harrison C, Hodge JC, Hu S, Jansen JH, Kanagal-Shamanna R, Kantarjian HM, Kratz CP, Li XQ, Lim MS, Loeb K, Loghavi S, Marcogliese A, Meshinchi S, Michaels P, Naresh KN, Natkunam Y, Nejati R, Ott G, Padron E, Patel KP, Patkar N, Picarsic J, Platzbecker U, Roberts I, Schuh A, Sewell W, Siebert R, Tembhare P, Tyner J, Verstovsek S, Wang W, Wood B, Xiao W, Yeung C, Hochhaus A. The 5th edition of the World Health Organization Classification of Haematolymphoid Tumours: Myeloid and Histiocytic/Dendritic Neoplasms. Leukemia. 2022;36(7):1703-1719.
- Raval SH, Joshi DV, Patel BJ, Patel JG, Bhatt NG. Histological and immunohistochemical characterisation of T-Cell Lymphoma in A Camel. J Camel Pract and Res. 2015;22(2):247?250.
- Tageldin MH, al Sumry HS, Zakia AM, Fayza AO. Suspicion of a case of lymphocytic leukaemia in a camel (Camelus dromedarius) in Sultanate of Oman. Rev Elev Med Vet Pays Trop. 1994;47(2):157?158.
- Twomey DF, Barlow AM, Hemsley S. Immunophenotyping of lymphosarcoma in South American camelids on six British premises. Vet J. 2008;175(1):133?135.
- Valli VE, Bienzle D, Meuten DJ. Tumors of the Hemolymphatic System. In: Tumors in Domestic Animals. 2016:203?321.
- Valli VE, Myint MS, Barthel A, et al. Classification of Canine Malignant Lymphomas According to the World Health Organization Criteria. Veterinary Pathology. 2010;48(1):198-211.